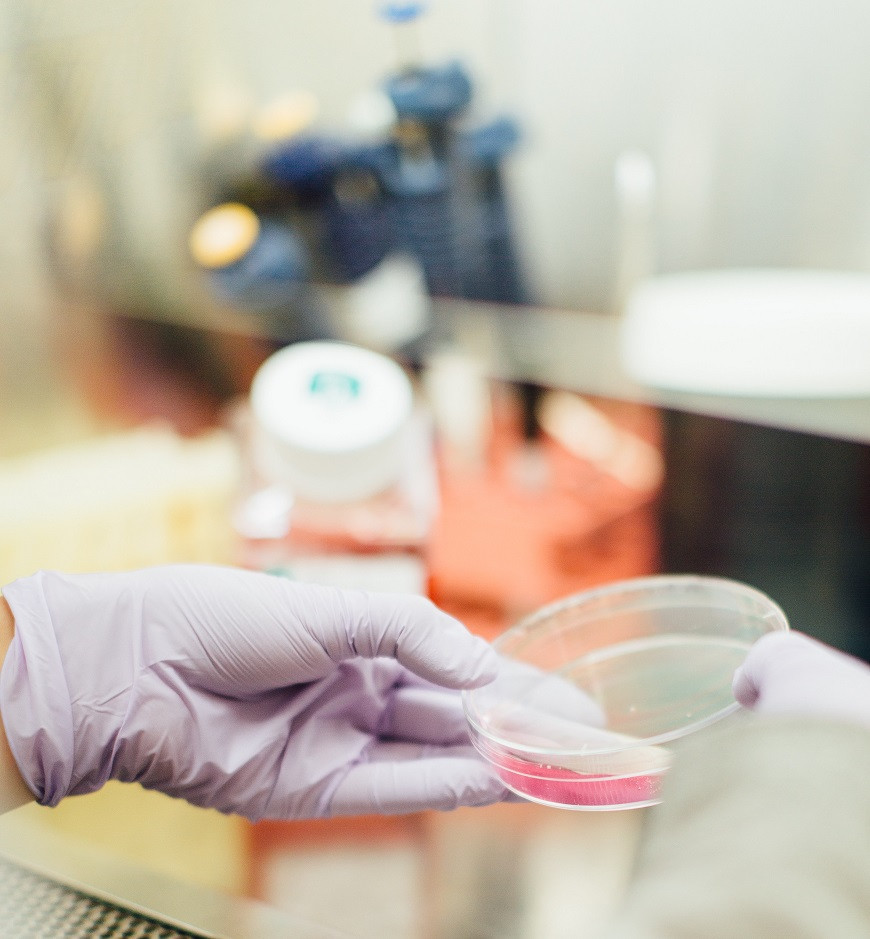
lab meat

Технологията, стояща зад месото от епруветка, не е разработена докрай


Технологията, стояща зад месото от епруветка, не е разработена докрай
Използваме информация, събирана чрез бисквитки и подобни технологии, за да подобрим вашето изживяване на нашия сайт, да анализираме как го използвате и за маркетингови цели.
Ние и нашите партньори използваме информация, събирана чрез бисквитки и подобни технологии, за да подобрим Вашето изживяване на нашия сайт, да анализираме начина, по който го използвате, и за маркетингови цели. Защото уважаваме Вашето право на лична сигурност, можете да изберете да не позволите някои видове бисквитки. Обаче, блокирането на някои видове бисквитки може да влоши Вашето изживяване на сайта и услугите, които можем да предложим. В някои случаи данните, получени от бисквитки, се споделят с трети страни за анализ или маркетингови цели. Можете да използвате своето право да откажете от тази споделена информация по всяко време, като деактивирате бисквитките.